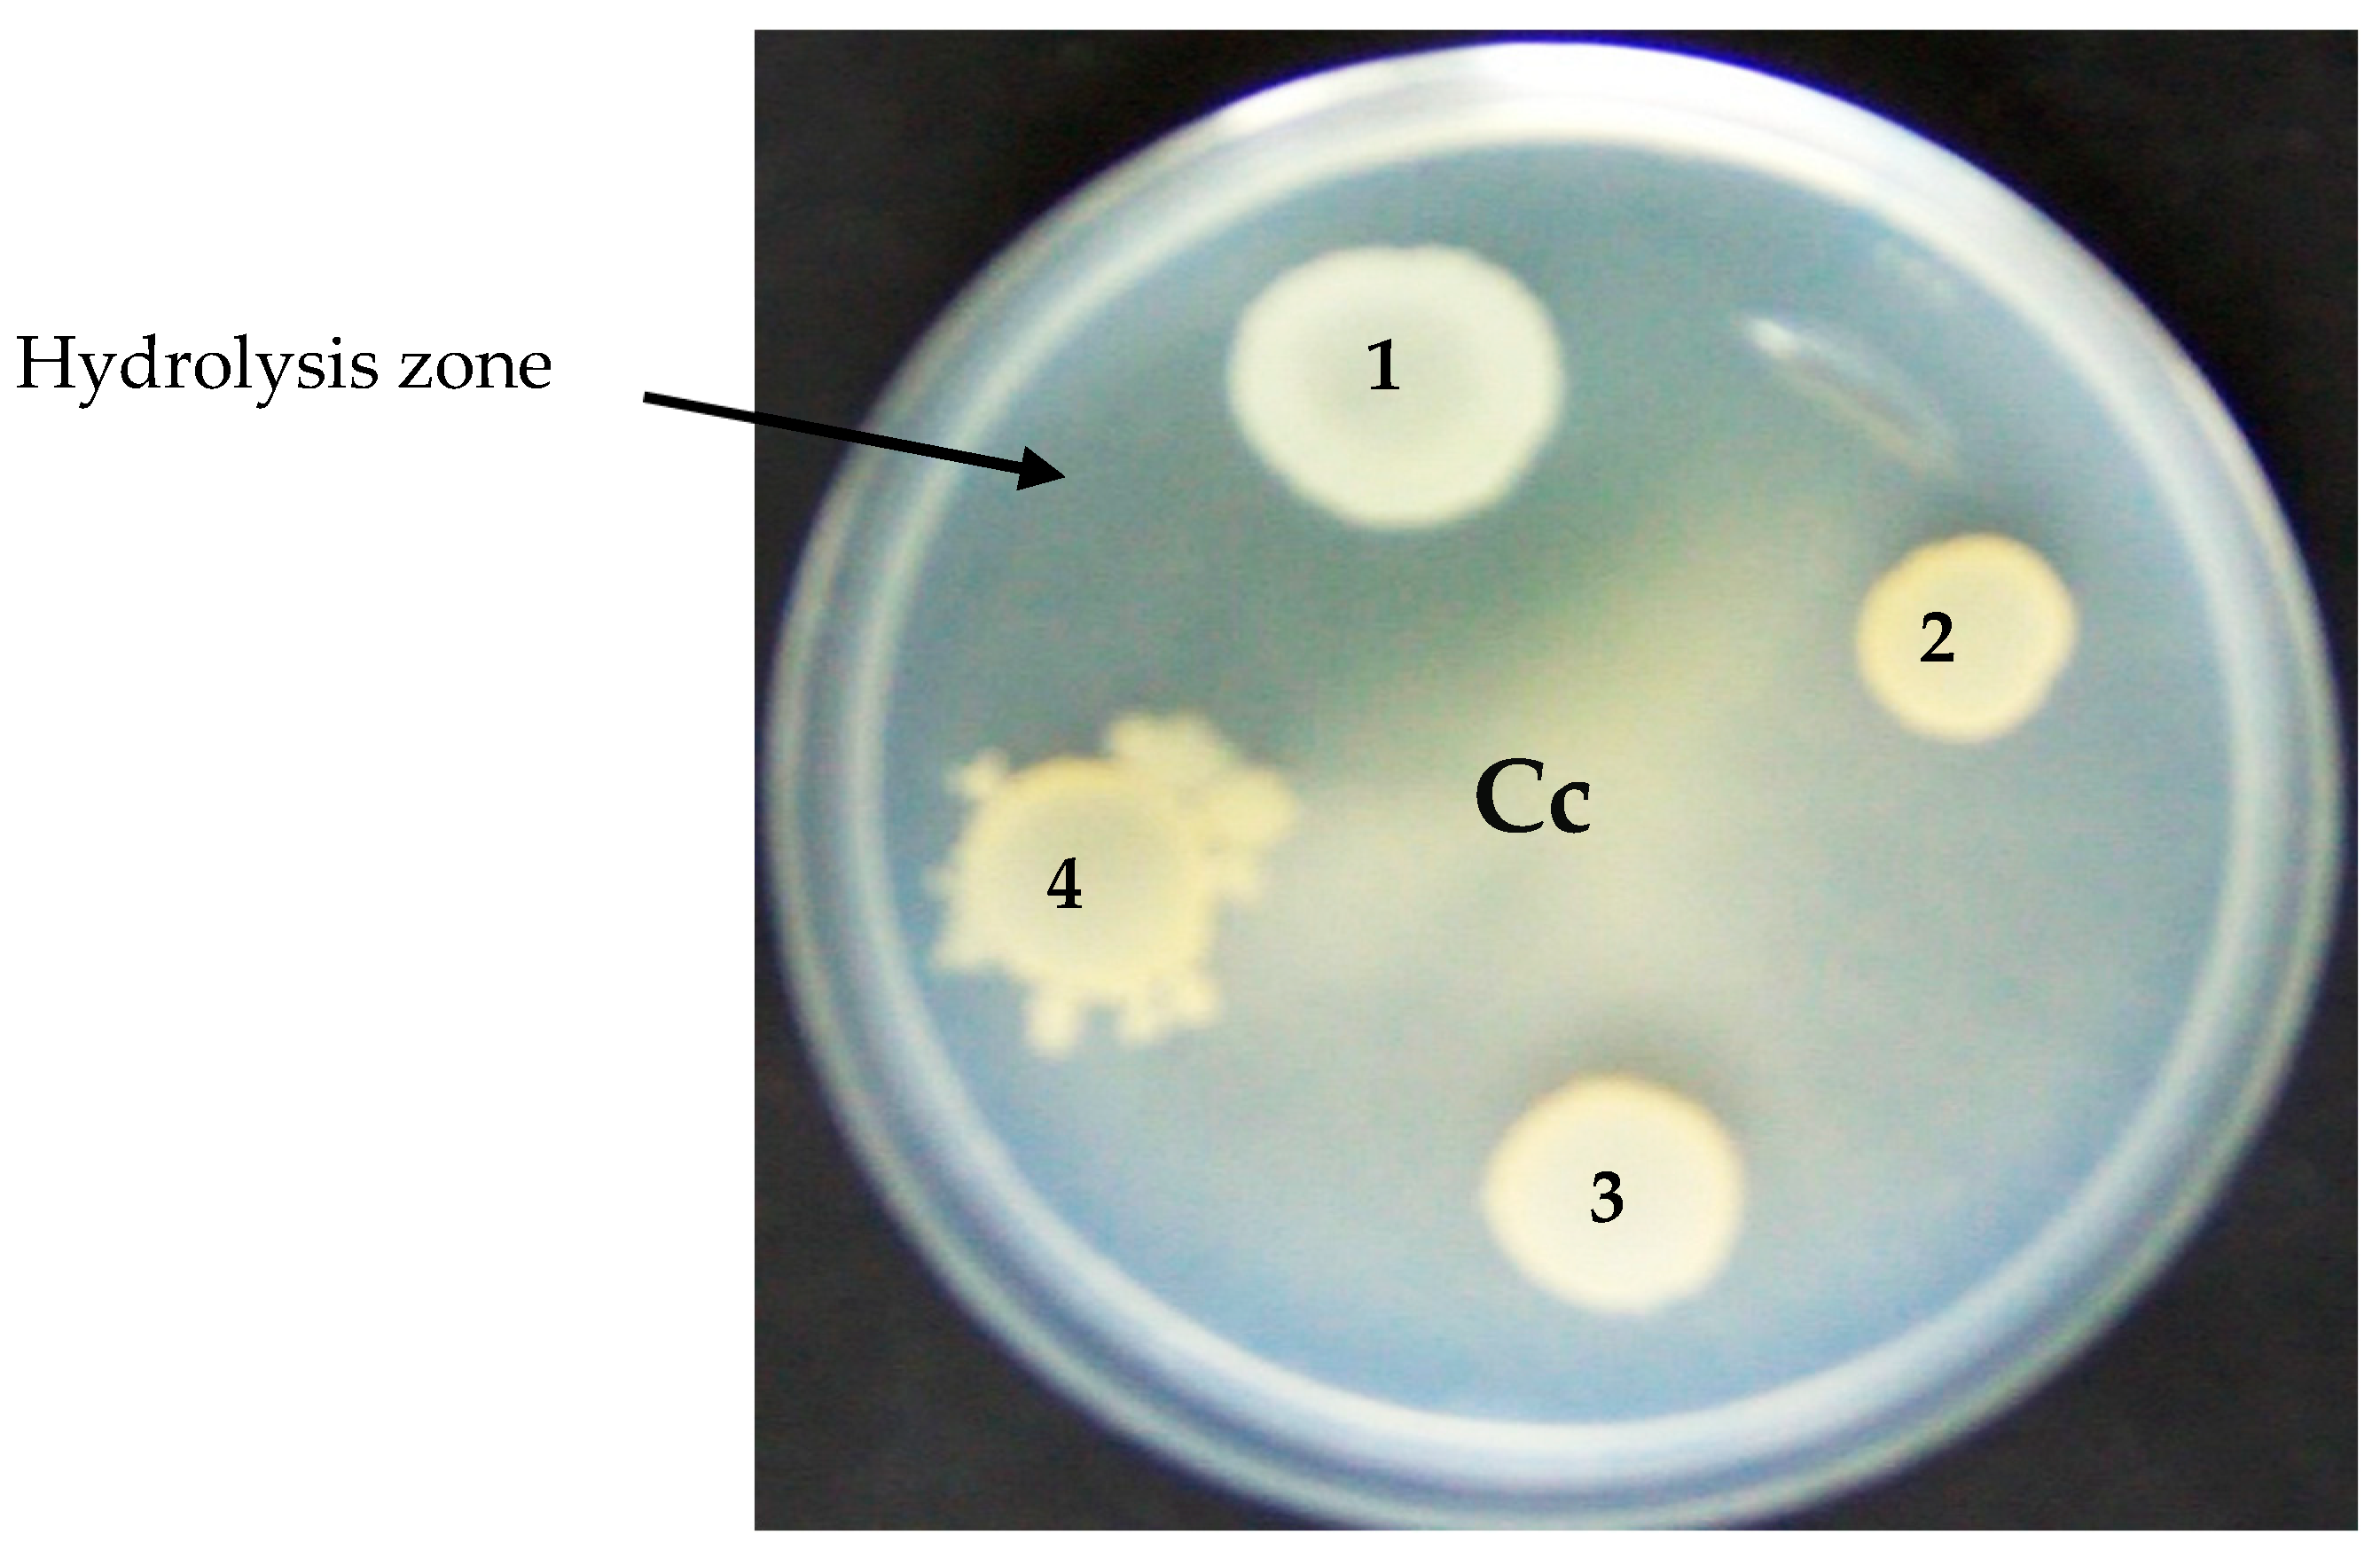
Microorganisms 12 01580 g002

Response Surface Methodology-Based Optimization of the Chitinolytic Activity of Burkholderia contaminans Strain 614 Exerting Biological Control against Phytopathogenic Fungi
Abstract
1. Introduction
2. Materials and Methods
2.1. Chitinase-Producing Bacteria
2.2. Cell Culture Conditions of S614 Strain
2.3. Isolate Identification
2.4. Colloidal Chitin Preparation and Chitinase Activity Assay
2.5. Experimental Design
2.6. Partial Purification of Chitinase Activity of S614 Strain
2.7. SDS-PAGE Analysis of the Chitinase Extract
2.8. Antifungal Activity of Chitinase
2.9. Chitinase Effect Using Detached Leaf Assay
2.10. Statistical Analysis
3. Results
3.1. Identification and Phylogenetic Relationship between Burkholderia Isolate and GenBank Database
3.2. Chitinase Activity
3.3. Model Fitting and Statistical Analysis
3.4. Response Surface Analysis for Chitinolytic Activity of Burkholderia Contaminans Strain 614
3.5. Optimization of Chitinase Activity of B. contaminans Strain 614
3.6. Partial Purification and Identification of Chitinase S614 Activity
3.7. In Vitro and in Planta Antifungal Activity of Chitinase
4. Discussion
5. Conclusions
Supplementary Materials
Author Contributions
Funding
Data Availability Statement
Acknowledgments
Conflicts of Interest
References
- Prasad, J.K.; Pandey, P.; Anand, R.; Raghuwanshi, R. Drought Exposed Burkholderia Seminalis JRBHU6 Exhibits Antimicrobial Potential through Pyrazine-1,4-Dione Derivatives Targeting Multiple Bacterial and Fungal Proteins. Front. Microbiol. 2021, 12, 633036. [Google Scholar] [CrossRef] [PubMed]
- Maiden, N.A.; Noran, A.S.; Ahmad Fauzi, M.A.F.; Atan, S. Screening and Characterisation of Chitinolytic Microorganisms with Potential to Control White Root Disease of Hevea Brasiliensis. J. Rubber Res. 2017, 20, 182–202. [Google Scholar] [CrossRef]
- Crini, G. Historical Review on Chitin and Chitosan Biopolymers. Environ. Chem. Lett. 2019, 17, 1623–1643. [Google Scholar] [CrossRef]
- Kim, M.-W.; Song, Y.-S.; Han, Y.S.; Jo, Y.H.; Choi, M.H.; Park, Y.-K.; Kang, S.H.; Kim, S.-A.; Choi, C.; Jung, W.-J. Production of Chitin and Chitosan from the Exoskeleton of Adult Two-Spotted Field Crickets (Gryllus bimaculatus): Chitin and Chitosan from G. bimaculatus. Entomol. Res. 2017, 47, 279–285. [Google Scholar] [CrossRef]
- Shahrajabian, M.H.; Chaski, C.; Polyzos, N.; Tzortzakis, N.; Petropoulos, S.A. Sustainable Agriculture Systems in Vegetable Production Using Chitin and Chitosan as Plant Biostimulants. Biomolecules 2021, 11, 819. [Google Scholar] [CrossRef] [PubMed]
- Srinivasan, H.; Kanayairam, V.; Ravichandran, R. Chitin and Chitosan Preparation from Shrimp Shells Penaeus Monodon and Its Human Ovarian Cancer Cell Line, PA-1. Int. J. Biol. Macromol. 2018, 107, 662–667. [Google Scholar] [CrossRef] [PubMed]
- Qu, T.; Zhang, C.; Qin, Z.; Fan, L.; Jiang, L.; Zhao, L. A Novel GH Family 20 β-N-Acetylhexosaminidase with Both Chitosanase and Chitinase Activity from Aspergillus oryzae. Front. Mol. Biosci. 2021, 8, 684086. [Google Scholar] [CrossRef] [PubMed]
- Kim, T.I.; Lim, D.H.; Baek, K.S.; Jang, S.S.; Park, B.Y.; Mayakrishnan, V. Production of Chitinase from Escherichia fergusonii, Chitosanase from Chryseobacterium indologenes, Comamonas koreensis and Its Application in N-Acetylglucosamine Production. Int. J. Biol. Macromol. 2018, 112, 1115–1121. [Google Scholar] [CrossRef]
- Kazami, N.; Sakaguchi, M.; Mizutani, D.; Masuda, T.; Wakita, S.; Oyama, F.; Kawakita, M.; Sugahara, Y. A Simple Procedure for Preparing Chitin Oligomers through Acetone Precipitation after Hydrolysis in Concentrated Hydrochloric Acid. Carbohydr. Polym. 2015, 132, 304–310. [Google Scholar] [CrossRef]
- Ajavakom, A.; Supsvetson, S.; Somboot, A.; Sukwattanasinitt, M. Products from Microwave and Ultrasonic Wave Assisted Acid Hydrolysis of Chitin. Carbohydr. Polym. 2012, 90, 73–77. [Google Scholar] [CrossRef]
- Joseph, S.M.; Krishnamoorthy, S.; Paranthaman, R.; Moses, J.A.; Anandharamakrishnan, C. A Review on Source-Specific Chemistry, Functionality, and Applications of Chitin and Chitosan. Carbohydr. Polym. Technol. Appl. 2021, 2, 100036. [Google Scholar] [CrossRef]
- Vaghela, B.; Vashi, R.; Rajput, K.; Joshi, R. Plant Chitinases and Their Role in Plant Defense: A Comprehensive Review. Enzyme Microb. Technol. 2022, 159, 110055. [Google Scholar] [CrossRef] [PubMed]
- Liu, T.; Duan, Y.; Yang, Q. Revisiting Glycoside Hydrolase Family 20 β-N-Acetyl-d-Hexosaminidases: Crystal Structures, Physiological Substrates and Specific Inhibitors. Biotechnol. Adv. 2018, 36, 1127–1138. [Google Scholar] [CrossRef] [PubMed]
- Singh, V.; Haque, S.; Niwas, R.; Srivastava, A.; Pasupuleti, M.; Tripathi, C.K.M. Strategies for Fermentation Medium Optimization: An In-Depth Review. Front. Microbiol. 2017, 7, 2087. [Google Scholar] [CrossRef] [PubMed]
- Tan, J.S.; Abbasiliasi, S.; Lee, C.K.; Phapugrangkul, P. Chitin Extraction from Shrimp Wastes by Single Step Fermentation with Lactobacillus acidophilus FTDC3871 Using Response Surface Methodology. J. Food Process. Preserv. 2020, 44, 14895. [Google Scholar] [CrossRef]
- Papagora, C.; Roukas, T.; Kotzekidou, P. Optimization of Extracellular Lipase Production by Debaryomyces hansenii Isolates from Dry-Salted Olives Using Response Surface Methodology. Food Bioprod. Process. 2013, 91, 413–420. [Google Scholar] [CrossRef]
- Singh, R.K.; Kumar, D.P.; Solanki, M.K.; Singh, P.; Srivastva, A.K.; Kumar, S.; Kashyap, P.L.; Saxena, A.K.; Singhal, P.K.; Arora, D.K. Optimization of Media Components for Chitinase Production by Chickpea Rhizosphere Associated Lysinibacillus fusiformis B-CM18: Optimization of Media Components for Chitinase Production. J. Basic Microbiol. 2013, 53, 451–460. [Google Scholar] [CrossRef] [PubMed]
- Suryawanshi, N.; Sahu, J.; Moda, Y.; Eswari, J.S. Optimization of Process Parameters for Improved Chitinase Activity from Thermomyces sp. by Using Artificial Neural Network and Genetic Algorithm. Prep. Biochem. Biotechnol. 2020, 50, 1031–1041. [Google Scholar] [CrossRef] [PubMed]
- Subramanian, K.; Sadaiappan, B.; Aruni, W.; Kumarappan, A.; Thirunavukarasu, R.; Srinivasan, G.P.; Bharathi, S.; Nainangu, P.; Renuga, P.S.; Elamaran, A.; et al. Bioconversion of Chitin and Concomitant Production of Chitinase and N-Acetylglucosamine by Novel Achromobacter Xylosoxidans Isolated from Shrimp Waste Disposal Area. Sci. Rep. 2020, 10, 11898. [Google Scholar] [CrossRef]
- Abdel Wahab, W.A.; Esawy, M.A. Statistical, Physicochemical, and Thermodynamic Profiles of Chitinase Production from Local Agro-Industrial Wastes Employing the Honey Isolate Aspergillus niger EM77. Heliyon 2022, 8, e10869. [Google Scholar] [CrossRef]
- Philip, N.V.; Koteshwara, A.; Kiran, G.A.; Raja, S.; Subrahmanyam, V.M.; Chandrashekar, H.R. Statistical Optimization for Coproduction of Chitinase and Beta 1, 4-Endoglucanase by Chitinolytic Paenibacillus elgii PB1 Having Antifungal Activity. Appl. Biochem. Biotechnol. 2020, 191, 135–150. [Google Scholar] [CrossRef] [PubMed]
- Sarker, K.N.; Das Mohapatra, P.K.; Dutta, S. Use of Low Cost Natural Resources for Enhanced Chitinase Production and Optimization Using CCD and RSM: A New Initiative for Bio-Control of Plant Pathogen. Indian Phytopathol. 2019, 72, 281–300. [Google Scholar] [CrossRef]
- Garima, D.; Anil, K. Statistical Optimization of Chitinase Production by Box–Behnken Design in Submerged Fermentation Using Bacillus Cereus GS02. J. Appl. Biol. Biotechnol. 2021, 9, 60–66. [Google Scholar] [CrossRef]
- Aounallah, M.A.; Slimene-Debez, I.B.; Djebali, K.; Gharbi, D.; Hammami, M.; Azaiez, S.; Limam, F.; Tabbene, O. Enhancement of Exochitinase Production by Bacillus licheniformis AT6 Strain and Improvement of N-Acetylglucosamine Production. Appl. Biochem. Biotechnol. 2017, 181, 650–666. [Google Scholar] [CrossRef] [PubMed]
- Slimene, I.B.; Tabbene, O.; Gharbi, D.; Mnasri, B.; Schmitter, J.M.; Urdaci, M.-C.; Limam, F. Isolation of a Chitinolytic Bacillus licheniformis S213 Strain Exerting a Biological Control against Phoma Medicaginis Infection. Appl. Biochem. Biotechnol. 2015, 175, 3494–3506. [Google Scholar] [CrossRef]
- Laemmli, U.K. Cleavage of Structural Proteins during the Assembly of the Head of Bacteriophage T4. Nature 1970, 227, 680–685. [Google Scholar] [CrossRef] [PubMed]
- Jin, Y.; Zhou, J.; Zhou, J.; Hu, M.; Zhang, Q.; Kong, N.; Ren, H.; Liang, L.; Yue, J. Genome-Based Classification of Burkholderia Cepacia Complex Provides New Insight into Its Taxonomic Status. Biol. Direct 2020, 15, 6. [Google Scholar] [CrossRef] [PubMed]
- Yurnaliza, Y.; Rambe, D.I.; Sarimunggu, L.; Purba, M.; Nurwahyuni, I.; Lenny, S.; Lutfia, A.; Hartanto, A. Screening of Burkholderia spp. from Oil Palm Plantation with Antagonistic Properties against Ganoderma boninense. Biodiversitas J. Biol. Divers. 2020, 21, 3431–3437. [Google Scholar] [CrossRef]
- Depoorter, E.; Bull, M.J.; Peeters, C.; Coenye, T.; Vandamme, P.; Mahenthiralingam, E. Burkholderia: An Update on Taxonomy and Biotechnological Potential as Antibiotic Producers. Appl. Microbiol. Biotechnol. 2016, 100, 5215–5229. [Google Scholar] [CrossRef]
- Schaefers, M.M. Regulation of Virulence by Two-Component Systems in Pathogenic Burkholderia. Infect. Immun. 2020, 88, e00927-19. [Google Scholar] [CrossRef]
- Tagele, S.B.; Kim, S.W.; Lee, H.G.; Kim, H.S.; Lee, Y.S. Effectiveness of Multi-Trait Burkholderia contaminans KNU17BI1 in Growth Promotion and Management of Banded Leaf and Sheath Blight in Maize Seedling. Microbiol. Res. 2018, 214, 8–18. [Google Scholar] [CrossRef] [PubMed]
- Meriem, G.; Mahmoud, K. Optimization of Chitinase Production by a New Streptomyces Griseorubens C9 Isolate Using Response Surface Methodology. Ann. Microbiol. 2017, 67, 175–183. [Google Scholar] [CrossRef]
- Cardozo, F.A.; Feitosa, V.; Mendonça, C.M.N.; da Silva, F.V.S.; Converti, A.; de Souza Oliveira, R.P.; Pessoa, A. Enhanced Production of N-Acetyl-Glucosaminidase by Marine Aeromonas caviae CHZ306 in Bioreactor. Braz. J. Microbiol. 2023, 54, 1533–1545. [Google Scholar] [CrossRef] [PubMed]
- Delfini, C.D.; Villegas, L.B.; Martínez, M.A.; Baigorí, M.D. Extracellular Antifungal Activity of Chitinase-Producing Bacteria Isolated From Guano of Insectivorous Bats. Curr. Microbiol. 2021, 78, 2787–2798. [Google Scholar] [CrossRef]
- Bassler, B.L.; Yu, C.; Lee, Y.C.; Rosmeman, S. Chitin Utilization by Marine Bacteria. Degradation and Catabolism of Chitin Oligosaccharides by Vibrio furnissii. J. Biol. Chem. 1991, 266, 24276–24286. [Google Scholar] [CrossRef] [PubMed]
- Li, X.; Roseman, S. The Chitinolytic Cascade in Vibrios Is Regulated by Chitin Oligosaccharides and a Two-Component Chitin Catabolic Sensor/Kinase. Proc. Natl. Acad. Sci. USA 2004, 101, 627–631. [Google Scholar] [CrossRef] [PubMed]
- Meibom, K.L.; Li, X.B.; Nielsen, A.T.; Wu, C.-Y.; Roseman, S.; Schoolnik, G.K. The Vibrio Cholerae Chitin Utilization Program. Proc. Natl. Acad. Sci. USA 2004, 101, 2524–2529. [Google Scholar] [CrossRef] [PubMed]
- Techkarnjanaruk, S.; Pongpattanakitshote, S.; Goodman, A.E. Use of a Promoterless lacZ Gene Insertion to Investigate Chitinase Gene Expression in the Marine Bacterium Pseudoalteromonas sp. Strain S9. Appl. Environ. Microbiol. 1997, 63, 2989–2996. [Google Scholar] [CrossRef] [PubMed]
- Asif, T.; Javed, U.; Zafar, S.B.; Ansari, A.; Ul Qader, S.A.; Aman, A. Bioconversion of Colloidal Chitin Using Novel Chitinase from Glutamicibacter uratoxydans Exhibiting Anti-Fungal Potential by Hydrolyzing Chitin Within Fungal Cell Wall. Waste Biomass Valorization 2020, 11, 4129–4143. [Google Scholar] [CrossRef]
- Dai, D.; Li, W.; Hu, W.; Sa, X. Effect of Medium Composition on the Synthesis of Chitinase and Chitin Deacetylase from Thermophilic Paenibacillus sp.Hul. Procedia Environ. Sci. 2011, 8, 620–628. [Google Scholar] [CrossRef]
- Saima; Kuddus, M.; Roohi; Ahmad, I.Z. Isolation of NOVEL chitinolytic Bacteria and Production Optimization of Extracellular Chitinase. J. Genet. Eng. Biotechnol. 2013, 11, 39–46. [Google Scholar] [CrossRef]
- Kumar, M.; Brar, A.; Vivekanand, V.; Pareek, N. Production of Chitinase from Thermophilic Humicola grisea and Its Application in Production of Bioactive Chitooligosaccharides. Int. J. Biol. Macromol. 2017, 104, 1641–1647. [Google Scholar] [CrossRef] [PubMed]
- Kotb, E.; Alabdalall, A.H.; Alghamdi, A.I.; Ababutain, I.M.; Aldakeel, S.A.; Al-Zuwaid, S.K.; Algarudi, B.M.; Algarudi, S.M.; Ahmed, A.A.; Albarrag, A.M. Screening for Chitin Degrading Bacteria in the Environment of Saudi Arabia and Characterization of the Most Potent Chitinase from Streptomyces variabilis Am1. Sci. Rep. 2023, 13, 11723. [Google Scholar] [CrossRef] [PubMed]
- Nguyen-Thi, N.; Doucet, N. Combining Chitinase C and N-Acetylhexosaminidase from Streptomyces coelicolor A3(2) Provides an Efficient Way to Synthesize N-Acetylglucosamine from Crystalline Chitin. J. Biotechnol. 2016, 220, 25–32. [Google Scholar] [CrossRef] [PubMed]
- Chen, F.; Chen, X.-Z.; Qin, L.-N.; Tao, Y.; Dong, Z.-Y. Characterization and Homologous Overexpression of an N-Acetylglucosaminidase Nag1 from Trichoderma reesei. Biochem. Biophys. Res. Commun. 2015, 459, 184–188. [Google Scholar] [CrossRef] [PubMed]
- Konno, N.; Takahashi, H.; Nakajima, M.; Takeda, T.; Sakamoto, Y. Characterization of β-N-Acetylhexosaminidase (LeHex20A), a Member of Glycoside Hydrolase Family 20, from Lentinula edodes (Shiitake Mushroom). AMB Express 2012, 2, 29. [Google Scholar] [CrossRef]
- Ren, J.H.; Ye, J.R.; Liu, H.; Xu, X.L.; Wu, X.Q. Isolation and Characterization of a New Burkholderia pyrrocinia Strain JK-SH007 as a Potential Biocontrol Agent. World J. Microbiol. Biotechnol. 2011, 27, 2203–2215. [Google Scholar] [CrossRef]

| Exp N° | Independent Variables | Experimental Value (YCA) | Predicted Values (YCA) | ||||
|---|---|---|---|---|---|---|---|
| (NH4)2SO4 (g/L) (X1) | K2HPO4 (g/L) (X2) | MgSO4 (g/L) (X3) | Chitin (g/L) (X4) | Yeast Extact (g/L) (X5) | Chitinase Activity (UA/mL) | Chitinase Activity (UA/mL) | |
| 1 | 7 (−1) | 1 (−1) | 0.1 (−1) | 5 (−1) | 0.5 (−1) | 0.3848 | 0.311541 |
| 2 | 14 (1) | 1 (−1) | 0.1 (−1) | 5 (−1) | 0.5 (−1) | 0.1720 | 0.149732 |
| 3 | 7 (−1) | 2 (1) | 0.1 (−1) | 5 (−1) | 0.5 (−1) | 0.1510 | 0.217698 |
| 4 | 14 (1) | 2 (1) | 0.1 (−1) | 5 (−1) | 0.5 (−1) | 0.2290 | 0.228439 |
| 5 | 7 (−1) | 1 (−1) | 0.2 (1) | 5 (−1) | 0.5 (−1) | 0.4284 | 0.496843 |
| 6 | 14 (1) | 1 (−1) | 0.2 (1) | 5 (−1) | 0.5 (−1) | 0.3114 | 0.335034 |
| 7 | 7 (−1) | 2 (1) | 0.2 (1) | 5 (−1) | 0.5 (−1) | 0.3428 | 0.260550 |
| 8 | 14 (1) | 2 (1) | 0.2 (1) | 5 (−1) | 0.5 (−1) | 0.3148 | 0.271291 |
| 9 | 7 (−1) | 1 (−1) | 0.1 (−1) | 10 (1) | 0.5 (−1) | 0.6412 | 0.663044 |
| 10 | 14 (1) | 1 (−1) | 0.1 (−1) | 10 (1) | 0.5 (−1) | 0.3308 | 0.301536 |
| 11 | 7 (−1) | 2 (1) | 0.1 (−1) | 10 (1) | 0.5 (−1) | 0.3646 | 0.462551 |
| 12 | 14 (1) | 2 (1) | 0.1 (−1) | 10 (1) | 0.5 (−1) | 0.2268 | 0.273592 |
| 13 | 7 (−1) | 1 (−1) | 0.2 (1) | 10 (1) | 0.5 (−1) | 0.8804 | 0.848346 |
| 14 | 14 (1) | 1 (−1) | 0.2 (1) | 10 (1) | 0.5 (−1) | 0.3128 | 0.486838 |
| 15 | 7 (−1) | 2 (1) | 0.2 (1) | 10 (1) | 0.5 (−1) | 0.4086 | 0.505403 |
| 16 | 14 (1) | 2 (1) | 0.2 (1) | 10 (1) | 0.5 (−1) | 0.3086 | 0.316444 |
| 17 | 7 (−1) | 1 (−1) | 0.1 (−1) | 5 (−1) | 1 (1) | 0.4472 | 0.491783 |
| 18 | 14 (1) | 1 (−1) | 0.1 (−1) | 5 (−1) | 1 (1) | 0.2432 | 0.329974 |
| 19 | 7 (−1) | 2 (1) | 0.1 (−1) | 5 (−1) | 1 (1) | 0.4446 | 0.397939 |
| 20 | 14 (1) | 2 (1) | 0.1 (−1) | 5 (−1) | 1 (1) | 0.3478 | 0.408681 |
| 21 | 7 (−1) | 1 (−1) | 0.2 (1) | 5 (−1) | 1 (1) | 0.6294 | 0.677085 |
| 22 | 14 (1) | 1 (−1) | 0.2 (1) | 5 (−1) | 1 (1) | 0.7018 | 0.515276 |
| 23 | 7 (−1) | 2 (1) | 0.2 (1) | 5 (−1) | 1 (1) | 0.4266 | 0.440791 |
| 24 | 14 (1) | 2 (1) | 0.2 (1) | 5 (−1) | 1 (1) | 0.499 | 0.451533 |
| 25 | 7 (−1) | 1 (−1) | 0.1 (−1) | 10 (1) | 1 (1) | 0.6424 | 0.843286 |
| 26 | 14 (1) | 1 (−1) | 0.1 (−1) | 10 (1) | 1 (1) | 0.5796 | 0.481777 |
| 27 | 7 (−1) | 2 (1) | 0.1 (−1) | 10 (1) | 1 (1) | 0.7054 | 0.642793 |
| 28 | 14 (1) | 2 (1) | 0.1 (−1) | 10 (1) | 1 (1) | 0.5526 | 0.453834 |
| 29 | 7 (−1) | 1 (−1) | 0.2 (1) | 10 (1) | 1 (1) | 1.1714 | 1.028588 |
| 30 | 14 (1) | 1 (−1) | 0.2 (1) | 10 (1) | 1 (1) | 0.6488 | 0.667079 |
| 31 | 7 (−1) | 2 (1) | 0.2 (1) | 10 (1) | 1 (1) | 0.7022 | 0.685645 |
| 32 | 14 (1) | 2 (1) | 0.2 (1) | 10 (1) | 1 (1) | 0.5228 | 0.496686 |
| 33 | 2.17 (−2.38) | 1.5 (0) | 0.15 (0) | 7.5 (0) | 0.75 (0) | 0.6608 | 0.583884 |
| 34 | 18.83 (2.38) | 1.5 (0) | 0.15 (0) | 7.5 (0) | 0.75 (0) | 0.1020 | 0.166749 |
| 35 | 10 (0) | 0.31 (−2.38) | 0.15 (0) | 7.5 (0) | 0.75 (0) | 0.5774 | 0.542832 |
| 36 | 10 (0) | 2.69 (2.38) | 0.15 (0) | 7.5 (0) | 0.75 (0) | 0.2062 | 0.228600 |
| 37 | 10 (0) | 1.5 (0) | 0.031 (−2.38) | 7.5 (0) | 0.75 (0) | 0.4750 | 0.388192 |
| 38 | 10 (0) | 1.5 (0) | 0.269 (2.38) | 7.5 (0) | 0.75 (0) | 0.6112 | 0.659514 |
| 39 | 10 (0) | 1.5 (0) | 0.15 (0) | 1.55 (−2.38) | 0.75 (0) | 0.2690 | 0.288000 |
| 40 | 10 (0) | 1.5 (0) | 0.15 (0) | 13.45 (2.38) | 0.75 (0) | 0.8450 | 0.759707 |
| 41 | 10 (0) | 1.5 (0) | 0.15 (0) | 7.5 (0) | 0.155 (−2.38) | 0.3652 | 0.309509 |
| 42 | 10 (0) | 1.5 (0) | 0.15 (0) | 7.5 (0) | 1.345 (2.38) | 0.5530 | 0.738198 |
| 43 | 10 (0) | 1.5 (0) | 0.15 (0) | 7.5 (0) | 0.75 (0) | 0.5454 | 0.523853 |
| 44 | 10 (0) | 1.5 (0) | 0.15 (0) | 7.5 (0) | 0.75 (0) | 0.4872 | 0.523853 |
| 45 | 10 (0) | 1.5 (0) | 0.15 (0) | 7.5 (0) | 0.75 (0) | 0.4910 | 0.523853 |
| 46 | 10 (0) | 1.5 (0) | 0.15 (0) | 7.5 (0) | 0.75 (0) | 0.5528 | 0.523853 |
| 47 | 10 (0) | 1.5 (0) | 0.15 (0) | 7.5 (0) | 0.75 (0) | 0.6120 | 0.523853 |
| YCA (R2 = 0.8525) | |||||
|---|---|---|---|---|---|
| Terms | Regression Coefficients a | Standard Error | t Value | p Value | |
| β0 | 0.523853 | 0.012205 | 42.9200 | >0.0001 | |
| β1 | −0.087692 | 0.007799 | −11.2436 | 0.000356 | |
| β11 | −0.026258 | 0.006923 | −3.7926 | 0.019226 | |
| β2 | −0.066059 | 0.007799 | −8.4699 | 0.001065 | |
| β22 | −0.024419 | 0.006923 | −3.5271 | 0.024295 | |
| β3 | 0.057039 | 0.007799 | 7.3133 | 0.001860 | |
| β4 | 0.099164 | 0.007799 | 12.7145 | 0.000220 | |
| β5 | 0.090121 | 0.007799 | 11.5550 | 0.000320 | |
| β12 | 0.043138 | 0.009074 | 4.7540 | 0.008944 | |
| β14 | −0.049925 | 0.009074 | −5.5021 | 0.005321 | |
| β23 | −0.035613 | 0.009074 | −3.9247 | 0.017179 | |
| β24 | −0.026663 | 0.009074 | −2.9384 | 0.042458 | |
| Source of variation | SS | DF | MS | F Value | p Value |
| Regression | 1.714030 | 11 | 0.15582087 | 18.3934692 | <0.0001 |
| Residuals | 0.296504 | 35 | 0.00847153 | ||
| Lack of fit | 0.2859647 | 31 | 0.00922467 | 3.50117873 | 0.1149 |
| Pure error | 0.01053893 | 4 | 0.00263473 | ||
| Total | 2.010533 | 46 | |||
| Name | Link | Strain | MW | Peptide Carte | % Recovery MS | Peptide Sequence |
|---|---|---|---|---|---|---|
| beta-N-acetylhexosaminidase | Q39CS2_BURS3 | Burkholderia lata (strain 383) | 90,135 | 14 | 20 |
|
Disclaimer/Publisher’s Note: The statements, opinions and data contained in all publications are solely those of the individual author(s) and contributor(s) and not of MDPI and/or the editor(s). MDPI and/or the editor(s) disclaim responsibility for any injury to people or property resulting from any ideas, methods, instructions or products referred to in the content. |
© 2024 by the authors. Licensee MDPI, Basel, Switzerland. This article is an open access article distributed under the terms and conditions of the Creative Commons Attribution (CC BY) license (https://creativecommons.org/licenses/by/4.0/).
Share and Cite
Ben Slimene Debez, I.; Houmani, H.; Mahmoudi, H.; Mkadmini, K.; Garcia-Caparros, P.; Debez, A.; Tabbene, O.; Djébali, N.; Urdaci, M.-C. Response Surface Methodology-Based Optimization of the Chitinolytic Activity of Burkholderia contaminans Strain 614 Exerting Biological Control against Phytopathogenic Fungi. Microorganisms 2024, 12, 1580. https://doi.org/10.3390/microorganisms12081580
Ben Slimene Debez I, Houmani H, Mahmoudi H, Mkadmini K, Garcia-Caparros P, Debez A, Tabbene O, Djébali N, Urdaci M-C. Response Surface Methodology-Based Optimization of the Chitinolytic Activity of Burkholderia contaminans Strain 614 Exerting Biological Control against Phytopathogenic Fungi. Microorganisms. 2024; 12(8):1580. https://doi.org/10.3390/microorganisms12081580
Chicago/Turabian StyleBen Slimene Debez, Imen, Hayet Houmani, Henda Mahmoudi, Khaoula Mkadmini, Pedro Garcia-Caparros, Ahmed Debez, Olfa Tabbene, Naceur Djébali, and Maria-Camino Urdaci. 2024. "Response Surface Methodology-Based Optimization of the Chitinolytic Activity of Burkholderia contaminans Strain 614 Exerting Biological Control against Phytopathogenic Fungi" Microorganisms 12, no. 8: 1580. https://doi.org/10.3390/microorganisms12081580
APA StyleBen Slimene Debez, I., Houmani, H., Mahmoudi, H., Mkadmini, K., Garcia-Caparros, P., Debez, A., Tabbene, O., Djébali, N., & Urdaci, M.-C. (2024). Response Surface Methodology-Based Optimization of the Chitinolytic Activity of Burkholderia contaminans Strain 614 Exerting Biological Control against Phytopathogenic Fungi. Microorganisms, 12(8), 1580. https://doi.org/10.3390/microorganisms12081580

